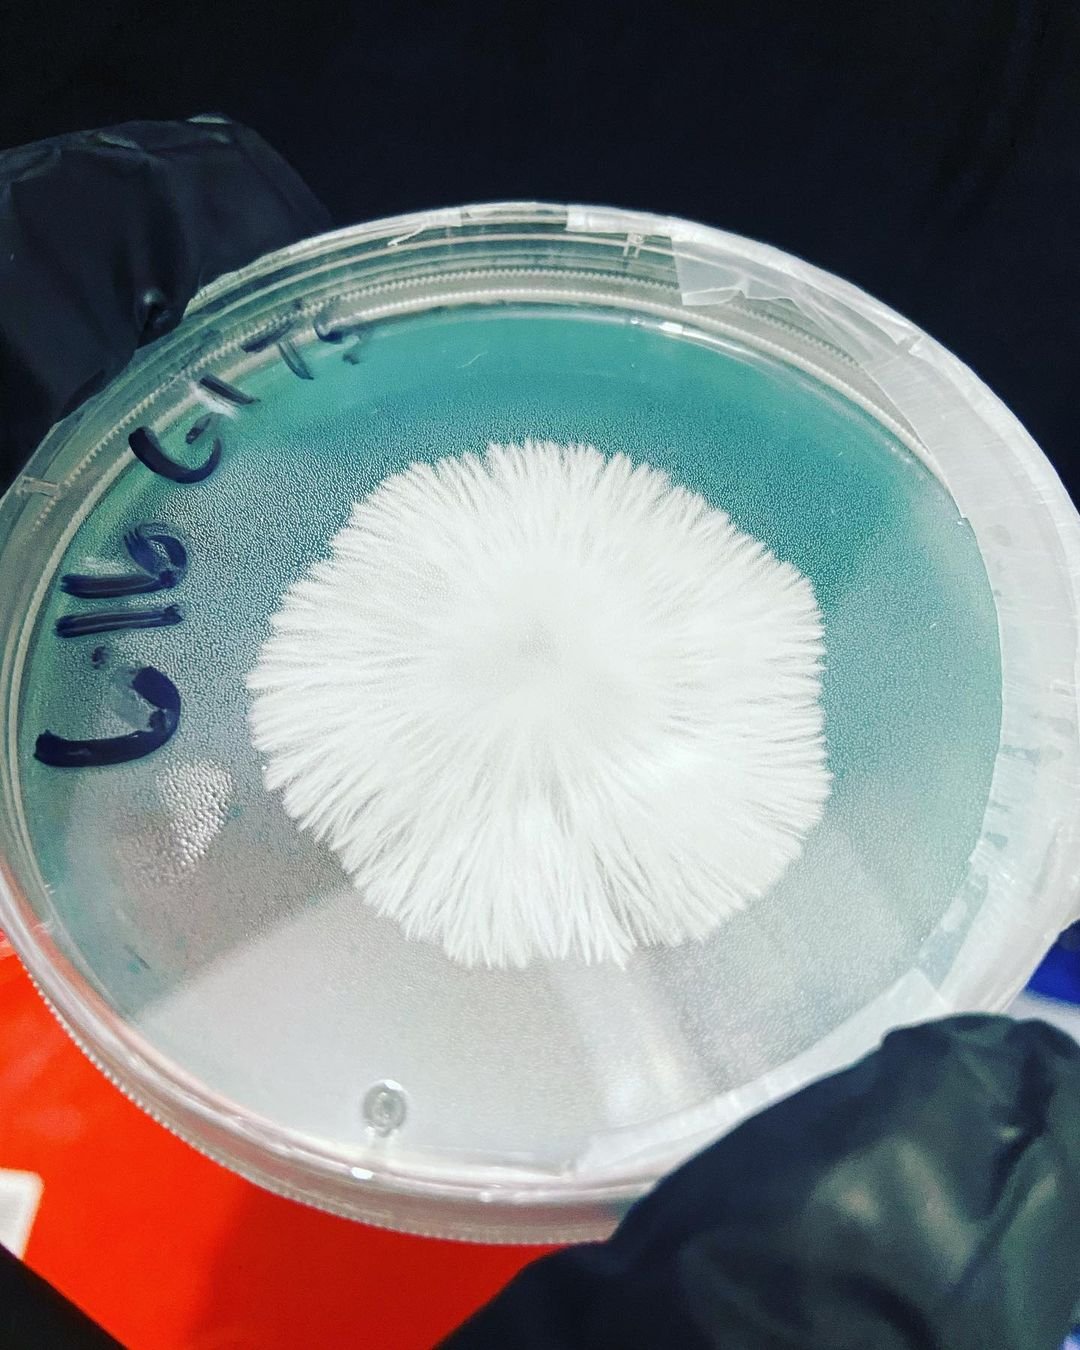
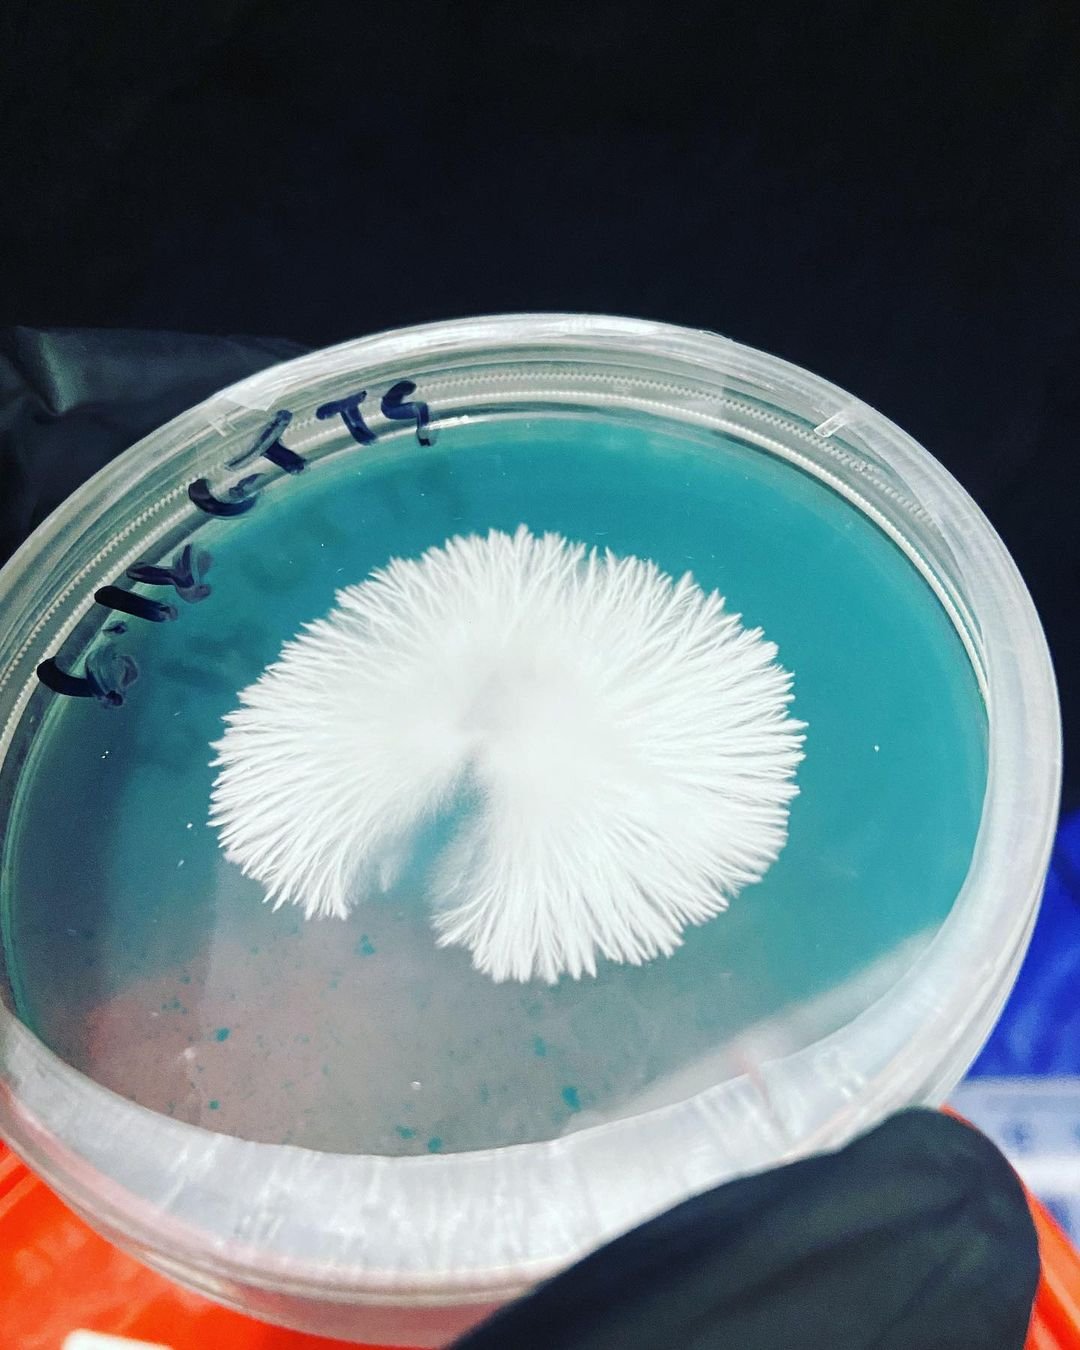

MonoTub
Golden Teachers, CVG (1:2.25).
Here are some of my recent projects. Feel free to contact me on any of my socials below!

Golden Teachers, CVG (1:2.25).

E4K, CVG (1:2.25).

PE#6, CVG (1:2.25).

PE#6 Close up

E4K Flush 2.

PE#6 colonizing a grain jar from agar.

E4K colonizing a grain jar from agar.
T5 means this is a 5th transfer from a MSS of GT.
T5 means this is a 5th transfer from a MSS of GT.